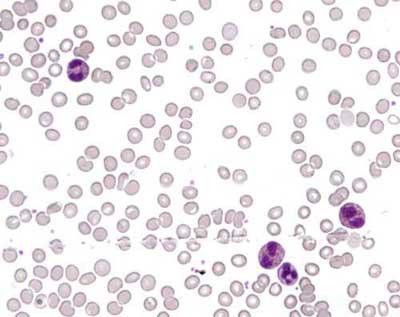

Labor Quiz 2
Eine 79jährige Patientin mit einer arteriellen Hypertonie kommt zur Routinekontrolle in Ihre Praxis. Da sie über eine AZ-Verschlechterung seit einigen Wochen berichtet veranlassen Sie einige Laboruntersuchungen.
Hier sehen Sie den Blutausstrich der 79jährigen Frau:
|
|
|
Blutausstrich | |
|
Frage 1
Welche Leukozyten-Kategorie ist in diesem Blutbild vorherrschend?
|
|
Frage 2
Welche weiteren Untersuchungen würden Sie auf jeden Fall veranlassen?
|
Sie schicken die Patientin zur weiteren Abklärung einem Hämatologen.
|
Frage 3
Welche Untersuchungen könnten bei der Differenzierung, ob es sich um eine primäre Eosinophilie (Myeloproliferatives Syndrom) oder um eine sekundäre Form (Cytokin gesteuerte Eosinophilenvermehrung) handelt, am ehesten helfen?
|
|
Frage 4
Was ist in der Situation dieser Patientin nun wichtiger?
|
Die vorliegenden Angaben stammen von Dr. med. Andreas Kuske in Bern.
Mediscope
02.03.2004 - dde